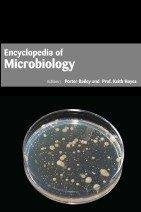
ENCYCLOPEDIA OF MICROBIOLOGY

GEOSTATISTICAL APPLICATIONS FOR PRECISION AGRICULTURE
Sale price
Rs.45,920
Regular price
Rs.51,025
Description
Book Details
- ISBN: 9781680942668
- Categories:
- Format: Hardback
- Publication Date: 2016
- Number of Pages: 298
- Author:
- Publisher: ARCLER PRESS
- Language: English
- Weight: 0.74 g